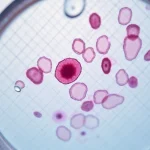

## Importance des Suppléments pendant la Grossesse
Comprendre l'importance des **suppléments de grossesse** est essentiel pour toute future maman. Ces produits jouent un rôle crucial dans le développement fœtal et assurent le bien-être nutritionnel de la mère. Les **bienfaits des suppléments** se manifestent particulièrement au travers de micronutriments essentiels qui peuvent ne pas toujours être fournis en quantité suffisante par l'alimentation quotidienne.
Des études montrent que les suppléments aident à prévenir les carences nutritionnelles qui pourraient affecter la santé des futures mamans. Par exemple, un approvisionnement adéquat en vitamines et minéraux est vital pour le développement sain du bébé. La **santé des futures mamans** est ainsi optimisée, ce qui réduit le risque de complications pendant la grossesse.
Prenons l'exemple de la vitamine D et du calcium, essentiels pour la formation osseuse du fœtus. Une supplémentation adaptée contribue donc à un déroulement optimal de la gestation. Sans oublier que ces suppléments peuvent aussi alléger certains inconforts courants chez les femmes enceintes, tels que la fatigue ou les crampes musculaires. Il est crucial de choisir judicieusement ces suppléments pour maximiser leurs effets bénéfiques.
Suppléments Recommandés pour les Futures Mamans
La supplémentation durant la grossesse est un sujet crucial pour assurer le bien-être des mères et de leurs futurs enfants.
Acide Folique
L’acide folique joue un rôle fondamental dans la prévention des malformations congénitales, notamment le spina-bifida. Les experts recommandent un dosage quotidien d’environ 400 à 800 microgrammes avant et pendant la grossesse. Cet élément vital peut être trouvé dans des aliments tels que les légumes verts à feuilles et le pain enrichi.
Dans le meme genre : Chambre de Bébé Inspirée par la Nature : Émerveillement et Astuces Décoratives
Fer
Le fer est essentiel pour prévenir l’anémie, une condition fréquente chez les futures mamans. Son absorption est facilitée par la vitamine C, et il trouve sa source dans des aliments comme les viandes rouges, les légumineuses, et les céréales enrichies. Les besoins en fer augmentent pendant la grossesse, mais une consommation excessive peut poser des problèmes de santé.
Oméga-3
Les oméga-3 sont cruciaux pour le développement cérébral et oculaire du fœtus. Il est recommandé que les femmes enceintes consomment environ 200 à 300 milligrammes par jour, en incluant des aliments riches en oméga-3 comme le poisson gras et les graines de lin. Ce composant aide également à réduire les inflammations et à réguler la pression artérielle.
A lire en complément : Choisir les chaussures idéales pour les femmes enceintes : astuces essentielles pour un confort optimal!
Considérations de Sécurité et d’Effets Secondaires
La sécurité autour des suppléments pendant la grossesse est primordiale pour éviter tout risque. Même si ces suppléments apportent des bienfaits, il est crucial de rester vigilant sur leur régulation. Les suppléments non régulés peuvent contenir des ingrédients inappropriés pour les femmes enceintes, entraînant des effets secondaires indésirables comme des nausées, des maux de tête ou des interactions médicamenteuses.
Les effets secondaires varient en fonction du type de supplément et de la dose consommée. Par exemple, un excès de vitamine A peut être toxique pour le développement fœtal. Pour éviter ces complications, il est recommandé de consulter un professionnel de la santé avant de débuter tout nouveau supplément. Cela assure une adaptation des doses à vos besoins spécifiques et évite les surdosages potentiellement nocifs.
Il est également essentiel de s’assurer que les suppléments utilisés proviennent de sources fiables et de suivre les recommandations des autorités sanitaires. Ainsi, vous garantirez la sécurité et le bien-être de votre grossesse en minimisant les risques associés à une supplémentation inappropriée.
Maintien d’une Alimentation Saine Pendant la Grossesse
Maintenir une alimentation saine est un élément clé pour assurer une grossesse optimale. Une nutrition prénatale appropriée soutient le développement du fœtus et préserve la santé de la mère.
Exemples d’un Régime Équilibré
Un régime alimentaire pendant la grossesse doit inclure une variété de groupes alimentaires essentiels. Ces groupes comprennent :
- Fruits et légumes: riches en vitamines et fibres, ils favorisent une bonne digestion et fournissent des nutriments essentiels.
- Protéines maigres: viandes blanches, poissons et légumineuses contribuent à la croissance fœtale.
- Grains entiers: sources d’énergie durable, ils sont importants pour la régulation du sucre dans le sang.
Des repas réguliers et nutritifs aident à maintenir un niveau d’énergie stable. Les recettes adaptées aux femmes enceintes peuvent inclure des plats simples et sains, intégrant une grande variété de nutriments.
Hydratation et ses Avantages
L’hydratation joue un rôle clé dans le soutien de la santé de la mère et du fœtus. Consommer environ 2 à 3 litres de liquides par jour est recommandé. L’hydratation peut aussi être assurée grâce à des aliments riches en eau comme les pastèques et concombres, aidant à répondre aux besoins hydriques quotidiens.